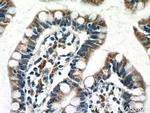
NAPRT1 Antibody in Immunohistochemistry (Paraffin) (IHC (P))

Search
Proteintech
NAPRT1 Monoclonal Antibody (5D8H10)
{{$productOrderCtrl.translations['antibody.pdp.commerceCard.promotion.promotions']}}
{{$productOrderCtrl.translations['antibody.pdp.commerceCard.promotion.viewpromo']}}
{{$productOrderCtrl.translations['antibody.pdp.commerceCard.promotion.promocode']}}: {{promo.promoCode}} {{promo.promoTitle}} {{promo.promoDescription}}. {{$productOrderCtrl.translations['antibody.pdp.commerceCard.promotion.learnmore']}}
产品信息
66159-1-IG
种属反应
宿主/亚型
分类
类型
克隆号
抗原
偶联物
形式
浓度
规格
纯化类型
保存液
内含物
保存条件
运输条件
产品详细信息
Immunogen sequence: MLAPAAGEG PGVDLAAKAQ VWLEQVCAHL GLGVQEPHPG ERAAFVAYAL AFPRAFQGLL DTYSVWRSGL PNFLAVALAL GELGYRAVGV RLDSGDLLQQ AQEIRKVFRA AAAQFQVPWL ESVLIVVSNN IDEEALARLA QEGSEVNVIG IGTSVVTCPQ QPSLGGVYKL VAVGGQPRMK LTEDPEKQTL PGSKAAFRLL GSDGSPLMDM LQLAEEPVPQ AGQELRVWPP GAQEPCTVRP AQVEPLLRLC LQQGQLCEPL PSLAESRALA QLSLSRLSPE HRRLRSPAQY QVVLSERLQA LVNSLCAGQS P (204-514 aa encoded by BC032466)
靶标信息
Nicotinic acid (NA; niacin) is converted by nicotinic acid phosphoribosyltransferase (NAPRT; EC 2.4.2.11) to NA mononucleotide (NaMN), which is then converted to NA adenine dinucleotide (NaAD), and finally to nicotinamide adenine dinucleotide (NAD), which serves as a coenzyme in cellular redox reactions and is an essential component of a variety of processes in cellular metabolism including response to stress (Hara et al., 2007).
仅用于科研。不用于诊断过程。未经明确授权不得转售。
生物信息学
蛋白别名: FHA-HIT-interacting protein; NAPRTase; Nicotinate phosphoribosyltransferase; nicotinate phosphoribosyltransferase domain containing 1; Nicotinate phosphoribosyltransferase domain-containing protein 1; nicotinic acid phosphoribosyltransferase
基因别名: 9130210N20Rik; FHIP; NAPRT; NAPRT1; PP3856
UniProt ID: (Human) Q6XQN6, (Mouse) Q8CC86
Entrez Gene ID: (Human) 93100, (Mouse) 223646